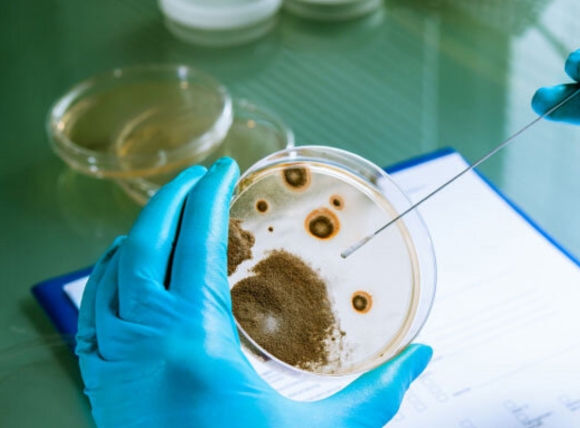
Tổng quan về yêu cầu vi sinh trong nước sản xuất thực phẩm theo QCVN
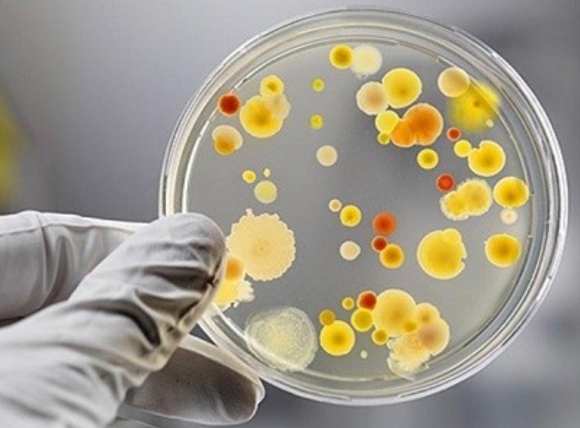
Tầm quan trọng của chỉ tiêu vi sinh trong nước sản xuất thực phẩm theo QCVN

Tiêu chuẩn nước sản xuất thực phẩm theo QCVN đóng vai trò quyết định trong việc đảm bảo an toàn vệ sinh và chất lượng sản phẩm thực phẩm tại Việt Nam.
Tuân thủ các quy chuẩn kỹ thuật quốc gia về nước - đặc biệt là QCVN 6-1:2010/BYT cho nước tiếp xúc trực tiếp và QCVN 01-1:2018/BYT cho nước sinh hoạt, không chỉ là yêu cầu bắt buộc từ Bộ Y tế mà còn là trách nhiệm của mọi doanh nghiệp chế biến thực phẩm đối với sức khỏe cộng đồng.
Tiêu chuẩn nước sản xuất thực phẩm theo QCVN quy định chặt chẽ 21 chỉ tiêu hóa lý và 5 chỉ tiêu vi sinh, yêu cầu nước phải trong suốt (độ đục <5 NTU), không màu, không mùi, không vị lạ, pH 6.0-8.5, không chứa vi khuẩn E.coli, Coliform và giới hạn kim loại nặng như Asen <0.01 mg/L.
Phân biệt rõ ràng giữa nước là thành phần trực tiếp sản phẩm (phải đạt QCVN 6-1:2010/BYT) và nước tiếp xúc gián tiếp (có thể dùng QCVN 01-1:2018/BYT) giúp doanh nghiệp tối ưu chi phí mà vẫn đảm bảo an toàn tối đa.
I. Các QCVN quy định tiêu chuẩn nước dùng trong sản xuất/chế biến thực phẩm
Quy chuẩn kỹ thuật quốc gia về chất lượng nước trong ngành chế biến thực phẩm được xây dựng dựa trên hệ thống văn bản pháp quy của Bộ Y tế và Bộ Tài nguyên Môi trường. Các cơ sở sản xuất cần nắm rõ từng quy chuẩn để áp dụng đúng theo mục đích sử dụng nước trong quy trình công nghệ.
1.1. Quy chuẩn chính thức - QCVN 6-1:2010/BYT
Quy chuẩn QCVN 6-1:2010/BYT là văn bản pháp lý quan trọng nhất cho các nhà máy chế biến thực phẩm. Quy chuẩn này được Bộ Y tế ban hành với tên đầy đủ là "Quy chuẩn kỹ thuật quốc gia đối với nước uống đóng chai và nước giải khát".
Phạm vi áp dụng của quy chuẩn này bao gồm:
- Nước tiếp xúc trực tiếp với sản phẩm cuối cùng: Khi nước chạm vào bề mặt thực phẩm trong bất kỳ giai đoạn nào của quy trình sản xuất.
- Nước làm thành phần cấu tạo: Sử dụng để pha chế đồ uống, nước súp, nước sốt, nước xốt.
- Nước dùng làm đá tiếp xúc thực phẩm: Các viên đá đựng cùng đồ uống hoặc dùng bảo quản nguyên liệu tươi sống.
- Nước rửa bao bì tiếp xúc sản phẩm: Làm sạch chai lọ, hộp đựng trước khi chiết rót.
- Hơi nước tiệt trùng: Dùng trong các thiết bị thanh trùng, khử khuẩn sản phẩm.
Quy chuẩn này quy định 21 chỉ tiêu hóa lý và 5 chỉ tiêu vi sinh phải được kiểm tra định kỳ. Đây là bộ thông số nghiêm ngặt nhất trong hệ thống quy chuẩn về nước tại Việt Nam.
---> Có thể bạn quan tâm [Xử lý nước thải ngành công nghiệp giấy, chế biến bột giấy]

1.2. Quy chuẩn liên quan - QCVN 01-1:2018/BYT
QCVN 01-1:2018/BYT mang tên "Quy chuẩn kỹ thuật quốc gia về chất lượng nước sạch sử dụng cho mục đích sinh hoạt". Văn bản này là phiên bản cập nhật của QCVN 01:2009/BYT, với nhiều điều chỉnh về giới hạn cho phép các chất ô nhiễm.
Quy chuẩn này cho phép áp dụng trong các trường hợp:
- Nước phục vụ mục đích phụ trợ: Các công đoạn không liên quan trực tiếp đến sản phẩm thực phẩm.
- Nước làm sạch thiết bị không tiếp xúc sản phẩm: Rửa các bộ phận máy móc, bình chứa nhiệt.
- Nước vệ sinh khu vực sản xuất: Lau chùi nền nhà xưởng, tường, cửa sổ khu vực làm việc.
- Hệ thống làm mát gián tiếp: Tháp giải nhiệt, bình ngưng không tiếp xúc với dòng sản phẩm.
Yêu cầu về chất lượng nước theo QCVN 01-1:2018/BYT vẫn phải tuân thủ các thông số về độ trong, màu sắc, mùi vị và vi sinh phù hợp với từng ứng dụng cụ thể trong nhà máy.
---> Có thể bạn quan tâm [Lọc cát đa tầng: Thiết kế đúng cách mang lại hiệu quả cao]

1.3. Quy chuẩn bổ sung - QCVN 40:2011/BTNMT
Quy chuẩn QCVN 40:2011/BTNMT do Bộ Tài nguyên và Môi trường ban hành. Quy chuẩn này quy định giới hạn các chất ô nhiễm trong nước thải công nghiệp khi xả ra môi trường.
Các cơ sở chế biến thực phẩm phải tuân thủ quy chuẩn này trong việc:
- Xử lý nước thải sau các công đoạn rửa nguyên liệu
- Kiểm soát nước thải từ hệ thống làm mát
- Xả thải nước từ quá trình vệ sinh nhà xưởng
- Quản lý nước thải từ các thiết bị xử lý nước ban đầu
Tuân thủ QCVN 40:2011/BTNMT không chỉ đáp ứng yêu cầu pháp luật mà còn thể hiện trách nhiệm của doanh nghiệp với môi trường xung quanh khu vực sản xuất.
---> Thông tin quan trọng có thể bạn quan tâm [5 Yếu tố đầu tư hệ thống lọc nước công nghiệp thành công]

1.4. Cơ quan ban hành QCVN
Bộ Y tế là cơ quan có thẩm quyền ban hành các quy chuẩn kỹ thuật quốc gia về chất lượng nước dùng trong sản xuất thực phẩm và nước sinh hoạt. Vai trò này được quy định rõ trong Luật An toàn thực phẩm năm 2010 và các văn bản hướng dẫn thi hành.
Chi cục An toàn vệ sinh thực phẩm trực thuộc Bộ Y tế chịu trách nhiệm giám sát việc thực thi các quy chuẩn này tại các cơ sở sản xuất trên toàn quốc. Các thanh tra viên có quyền lấy mẫu nước định kỳ hoặc đột xuất để kiểm tra mức độ tuân thủ của doanh nghiệp.
---> Các thông tin có liên quan về lọc nước công nghiệp [Cặn bám tháp giải nhiệt: 3 Nguyên nhân & Giải pháp]
II. Các chỉ tiêu vi sinh vật cần đạt trong nước sản xuất thực phẩm theo QCVN
Vi sinh vật là mối nguy hiểm lớn nhất trong nước dùng cho chế biến thực phẩm. Một lượng vi khuẩn gây bệnh cực nhỏ có thể phát triển nhanh chóng và gây ô nhiễm hàng loạt sản phẩm.
2.1. Tổng quan về yêu cầu vi sinh
Theo QCVN 6-1:2010/BYT, nước sản xuất thực phẩm phải đạt 5 chỉ tiêu vi sinh bắt buộc. Đây là các thông số không được phép vi phạm dưới bất kỳ trường hợp nào. Ngay cả một lần phát hiện vi khuẩn vượt ngưỡng cũng cần dừng sản xuất ngay lập tức.Yêu cầu chung bao trùm tất cả các chỉ tiêu vi sinh là: nước không được chứa vi sinh vật gây bệnh.
Điều này có nghĩa là:
- Vi khuẩn đường ruột phải ở mức "không phát hiện"
- Virus gây bệnh đường tiêu hóa phải ở mức "không phát hiện"
- Nấm men, nấm mốc gây hại phải được kiểm soát
- Ký sinh trùng đơn bào phải ở mức "không phát hiện"
Các phòng thí nghiệm được chỉ định sử dụng phương pháp chuẩn để phân tích mẫu nước. Thể tích mẫu thử nghiệm thường là 100ml hoặc 250ml tùy theo chỉ tiêu cụ thể.
---> Có thể bạn quan tâm về [Nước làm mát tháp giải nhiệt: Chống cặn & Ăn mòn]
2.2. Các chỉ tiêu vi sinh bắt buộc
|
Chỉ tiêu vi sinh
|
Giới hạn cho phép
|
Ý nghĩa kiểm soát
|
|
E. coli
|
0 CFU/100ml
|
Chỉ báo ô nhiễm phân người và động vật, nguy cơ nhiễm khuẩn đường ruột
|
|
Coliform
|
0 CFU/100ml
|
Nhóm vi khuẩn chỉ thị vệ sinh, báo hiệu ô nhiễm từ môi trường
|
|
Tổng số vi khuẩn hiếu khí
|
Dưới 100 CFU/ml
|
Đánh giá mức độ sạch tổng thể của nguồn nước
|
|
Pseudomonas aeruginosa
|
0 CFU/250ml
|
Vi khuẩn gây bệnh đường hô hấp và nhiễm trùng da
|
|
Streptococci faecal
|
0 CFU/100ml
|
Chỉ thị ô nhiễm phân, kháng với điều kiện khắc nghiệt hơn E.coli
|
E.coli và Coliform là hai chỉ tiêu được kiểm tra thường xuyên nhất. E.coli sống trong ruột người và động vật máu nóng, sự xuất hiện của chúng chứng tỏ nước bị nhiễm phân. Coliform là nhóm vi khuẩn rộng hơn, bao gồm cả các loài sống trong đất và nước, nhưng sự hiện diện của chúng vẫn cảnh báo về vệ sinh kém.
Pseudomonas aeruginosa là vi khuẩn có khả năng gây nhiễm trùng nghiêm trọng, đặc biệt nguy hiểm với người có hệ miễn dịch yếu. Loại vi khuẩn này thường phát triển trong các đường ống nước và bể chứa không được vệ sinh đúng cách.
Streptococci faecal có khả năng tồn tại lâu hơn E.coli trong môi trường nước. Việc kiểm tra chỉ tiêu này giúp phát hiện ô nhiễm phân cũ mà các vi khuẩn khác đã chết do điều kiện bất lợi.
---> Có thể bạn quan tâm [Quy trình xử lý nước bể bơi (Hồ bơi) chi tiết từ A-Z]
2.3. Tầm quan trọng của các chỉ tiêu vi sinh
Vi khuẩn trong nước sản xuất có thể gây ra các hậu quả nghiêm trọng:
Đối với sản phẩm thực phẩm:
- Gây hư hỏng sản phẩm, giảm thời hạn sử dụng
- Tạo mùi vị lạ, làm mất chất lượng cảm quan
- Phát triển độc tố trong quá trình bảo quản
- Dẫn đến cần thu hồi sản phẩm trên thị trường
Đối với sức khỏe người tiêu dùng:
- Gây ngộ độc thực phẩm cấp tính với triệu chứng nôn mửa, tiêu chảy
- Nhiễm khuẩn đường ruột kéo dài, mất nước nghiêm trọng
- Nguy hiểm đặc biệt với trẻ em, người cao tuổi, phụ nữ mang thai
- Có thể dẫn đến tử vong trong các trường hợp nhiễm trùng huyết
Đối với doanh nghiệp:
- Mất uy tín thương hiệu, giảm doanh số
- Chi phí bồi thường cho người tiêu dùng bị ảnh hưởng
- Bị xử phạt hành chính, tạm ngưng hoặc thu hồi giấy phép
- Tốn kém cho việc xử lý sự cố và khắc phục hệ thống
Vì những lý do này, yêu cầu "không phát hiện" vi sinh vật gây bệnh là tuyệt đối cần thiết. Không có ngưỡng an toàn nào cho các vi khuẩn này trong nước sản xuất thực phẩm.
---> Hãy tìm hiểu thêm về [Hệ thống lọc RO là gì? Nguyên lý hoạt động chi tiết]
III. Các chỉ tiêu hóa lý theo QCVN mà nước dùng trong sản xuất thực phẩm cần đạt
Các thông số hóa học và vật lý của nước ảnh hưởng trực tiếp đến chất lượng sản phẩm cuối cùng. Nước có độ cứng cao có thể tạo cặn trong thiết bị, nước chứa kim loại nặng gây nguy hiểm cho sức khỏe.
3.1. Chỉ tiêu cảm quan
Chỉ tiêu cảm quan là những đặc tính mà con người có thể nhận biết bằng các giác quan. Đây là nhóm chỉ tiêu đầu tiên cần kiểm tra trước khi đưa nước vào sử dụng:
- Độ trong suốt: Nước phải có độ đục nhỏ hơn 5 NTU (đơn vị đục đo theo phương pháp đo độ đục nephelometric). Nước đục chứa các hạt lơ lửng có thể là bùn đất, vi sinh vật hoặc tạp chất hữu cơ.
- Màu sắc: Nước hoàn toàn không màu. Nước có màu vàng có thể chứa sắt hoặc mangan. Màu nâu đen chỉ thị sự hiện diện của chất hữu cơ phân hủy. Màu xanh lục thường do tảo phát triển.
- Mùi: Nước không có mùi lạ. Mùi tanh thường do vi sinh vật. Mùi hóa chất có thể từ clo dư hoặc các chất xử lý khác. Mùi thối báo hiệu ô nhiễm chất hữu cơ.
- Vị: Nước không có vị lạ. Vị mặn do muối hòa tan cao. Vị kim loại từ sắt hoặc đồng trong đường ống. Vị đắng có thể do mangan hoặc một số hợp chất hữu cơ.
Các chỉ tiêu cảm quan tuy không gây hại trực tiếp nhưng ảnh hưởng lớn đến chất lượng thực phẩm. Nước có màu sắc, mùi vị lạ sẽ làm thay đổi đặc tính của sản phẩm cuối cùng, khiến người tiêu dùng từ chối mua.
---> Có thể bạn quan tâm [EDI: Công nghệ tạo nước siêu tinh khiết không dùng hóa chất]

3.2. Chỉ tiêu hóa học quan trọng
|
Chỉ tiêu hóa lý
|
Giới hạn cho phép
|
Tác động khi vượt chuẩn
|
|
pH (độ pH)
|
6.0 - 8.5
|
pH thấp (<6) ăn mòn thiết bị; pH cao (>8.5) làm giảm hiệu quả khử trùng
|
|
Độ đục
|
< 5 NTU
|
Che chở vi khuẩn khỏi tia UV, giảm hiệu quả diệt khuẩn
|
|
Độ cứng tổng
|
< 300 mg/L (tính theo CaCO₃)
|
Tạo cặn canxi-magie trong đường ống và thiết bị gia nhiệt
|
|
TDS (Tổng chất rắn hòa tan)
|
< 500 mg/L
|
Vị mặn, ảnh hưởng hương vị sản phẩm
|
|
Asen (As)
|
< 0.01 mg/L
|
Gây ung thư, tích lũy trong cơ thể gây độc mãn tính
|
|
Chì (Pb)
|
< 0.01 mg/L
|
Gây độc thần kinh, ảnh hưởng phát triển trẻ em
|
|
Thủy ngân (Hg)
|
< 0.001 mg/L
|
Gây tổn thương não, thận, hệ thần kinh
|
|
Clo dư tự do
|
0.3 - 0.5 mg/L
|
Quá cao gây mùi vị khó chịu, quá thấp không đủ khử trùng
|
Độ pH ảnh hưởng đến nhiều quá trình hóa học trong nước. pH thấp làm tăng khả năng hòa tan kim loại nặng từ đường ống. pH cao làm giảm tác dụng của clo trong khử trùng và tạo kết tủa canxi.
Độ cứng do ion canxi và magie gây ra. Nước cứng tạo cặn trong nồi hơi, làm giảm hiệu suất truyền nhiệt. Cặn tích tụ trong các van, ống dẫn gây tắc nghẽn. Nước cứng cũng làm giảm tác dụng của xà phòng và chất tẩy rửa.
TDS đo tổng lượng chất rắn hòa tan trong nước. TDS cao làm nước có vị mặn, ảnh hưởng đến hương vị đồ uống. Nước có TDS quá cao cũng khó xử lý bằng các phương pháp lọc thông thường.
---> Nếu bạn quan tâm hãy tham khảo [Báo giá máy lọc nước cho nhà máy, nhà xưởng, công ty]
3.3. Các chất cần kiểm soát
Ngoài các chỉ tiêu chính, còn có nhiều chất khác cần được kiểm soát trong nước sản xuất thực phẩm:
Kim loại nặng:
- Cadimi gây tổn thương thận, loãng xương
- Crom sáu hóa trị gây ung thư
- Đồng làm hư hỏng gan khi tích lũy
- Kẽm gây rối loạn tiêu hóa nếu dư thừa
Hóa chất vô cơ:
- Nitrat và nitrit gây methemoglobinemia (bệnh xanh da) ở trẻ sơ sinh
- Fluoride quá cao gây nhiễm độc fluor, hư răng
- Xianua cực độc, gây ngạt tế bào
- Amoniac chỉ thị ô nhiễm hữu cơ
Hóa chất hữu cơ:
- Phenol và các dẫn xuất gây mùi vị lạ ngay ở nồng độ rất thấp
- Thuốc trừ sâu tích lũy gây rối loạn nội tiết
- Dầu mỡ khoáng làm ô nhiễm bề mặt, gây mùi khó chịu
- Các chất hoạt động bề mặt từ nước thải công nghiệp
Chất phóng xạ:
- Phóng xạ tổng alpha và beta phải dưới ngưỡng quy định
- Uranium tự nhiên trong một số nguồn nước ngầm
- Radon từ đá phóng xạ trong lòng đất
---> Tham khảo thông tin liên quan [Chống ăn mòn & Cặn bám nồi hơi: 3 Nguyên nhân & Giải pháp]

3.4. Tổng số chỉ tiêu
QCVN 6-1:2010/BYT quy định tổng cộng 21 chỉ tiêu hóa lý phải được kiểm tra. Đây là bộ chỉ tiêu toàn diện nhất trong các quy chuẩn về nước tại Việt Nam. Mỗi chỉ tiêu có giới hạn cho phép riêng dựa trên nghiên cứu khoa học và khuyến nghị của Tổ chức Y tế Thế giới.
Việc kiểm tra đầy đủ 21 chỉ tiêu này đòi hỏi:
- Phòng thí nghiệm có đầy đủ thiết bị phân tích hiện đại
- Nhân viên kỹ thuật được đào tạo chuyên sâu
- Chi phí kiểm nghiệm từ vài triệu đến chục triệu đồng mỗi lần
- Thời gian phân tích từ 3 đến 7 ngày làm việc
Doanh nghiệp cần lập kế hoạch kiểm nghiệm định kỳ, thường là mỗi tháng hoặc mỗi quý tùy theo quy mô sản xuất và yêu cầu của cơ quan quản lý.
---> Thông tin uy tín đáng để bạn quan tâm [Lắp đặt hệ thống lọc nước RO chạy thận nhân tạo đạt chuẩn Bộ Y Tế tại VITEKO]
IV. Sự khác biệt giữa tiêu chuẩn nước sinh hoạt và nước sản xuất thực phẩm
Nhiều doanh nghiệp nhầm lẫn giữa nước sinh hoạt và nước sản xuất thực phẩm. Sự khác biệt này quyết định việc lựa chọn hệ thống xử lý và chi phí đầu tư.
4.1. Nước sinh hoạt - QCVN 01-1:2018/BYT
Nước sinh hoạt theo quy chuẩn này phục vụ các nhu cầu sinh hoạt hàng ngày của con người. Trong bối cảnh sản xuất thực phẩm, nước sinh hoạt được phép sử dụng cho:
- Vệ sinh các khu vực không tiếp xúc sản phẩm: hành lang, phòng thay đồ, kho nguyên liệu khô
- Làm mát thiết bị qua hệ thống trao đổi nhiệt kín (không trực tiếp)
- Rửa sơ bộ các dụng cụ trước khi vệ sinh tinh bằng nước tinh khiết
- Tưới cây xanh trong khuôn viên nhà máy
- Sử dụng trong nhà vệ sinh, phòng tắm cho công nhân
---> Tham khảo các hệ thống lọc nước công nghiệp chất lượng của VITEKO [TẠI ĐÂY]
Yêu cầu về chất lượng nước sinh hoạt vẫn phải tuân thủ các ngưỡng về độ trong, màu sắc và vi sinh. Tuy nhiên, một số chỉ tiêu hóa học có giới hạn cao hơn so với nước uống trực tiếp. Điều này cho phép nguồn nước từ các hệ thống cấp nước đô thị đáp ứng mà không cần xử lý quá phức tạp.

4.2. Nước sản xuất thực phẩm/nước uống đóng chai - QCVN 6-1:2010/BYT
Nước sản xuất thực phẩm phải đạt tiêu chuẩn như nước uống đóng chai. Quy chuẩn này áp dụng bắt buộc khi nước:
- Trở thành thành phần của sản phẩm: nước trong các loại nước giải khát, nước trái cây, nước súp, nước tương
- Tiếp xúc trực tiếp với nguyên liệu: Rửa rau quả, ngâm đậu đỗ, luộc thực phẩm
- Làm đá để bảo quản: Đá viên cho hải sản tươi sống, đá bào cho sinh tố
- Vệ sinh bề mặt tiếp xúc sản phẩm: Rửa băng tải, bình chứa, van đóng chai
- Sản xuất hơi nước trực tiếp: Hơi phun vào sản phẩm để thanh trùng
Các chỉ tiêu trong QCVN 6-1:2010/BYT nghiêm ngặt hơn đáng kể:
- Vi sinh: "Không phát hiện" thay vì "dưới ngưỡng cho phép"
- Kim loại nặng: Giới hạn thấp hơn 30-50% so với nước sinh hoạt
- Hóa chất hữu cơ: Kiểm tra thêm các chất như phenol, dầu khoáng
- Chất phóng xạ: Bổ sung kiểm tra phóng xạ alpha và beta
---> Nội dung liên quan nên tham khảo [Công nghệ xử lý nước cấp cho nhà máy chế biến sữa]
Sử dụng nước đạt chuẩn QCVN 6-1:2010/BYT cho tất cả các mục đích trong nhà máy là biện pháp an toàn nhất. Mặc dù chi phí xử lý cao hơn, nhưng loại bỏ được rủi ro sử dụng nhầm nguồn nước không đạt chuẩn.

4.3. Bảng so sánh tổng quan
|
Tiêu chí so sánh
|
QCVN 01-1:2018/BYT (Nước sinh hoạt)
|
QCVN 6-1:2010/BYT (Nước sản xuất thực phẩm)
|
|
Mức độ tiếp xúc với sản phẩm
|
Gián tiếp, không chạm vào thực phẩm
|
Trực tiếp hoặc là thành phần sản phẩm
|
|
Số chỉ tiêu vi sinh
|
3-4 chỉ tiêu cơ bản
|
5 chỉ tiêu bắt buộc
|
|
Yêu cầu E.coli
|
< 3 CFU/100ml có thể chấp nhận trong một số trường hợp
|
0 CFU/100ml - không phát hiện tuyệt đối
|
|
Số chỉ tiêu hóa lý
|
15-18 chỉ tiêu
|
21 chỉ tiêu đầy đủ
|
|
Giới hạn Asen
|
< 0.05 mg/L
|
< 0.01 mg/L
|
|
Giới hạn TDS
|
< 1000 mg/L
|
< 500 mg/L
|
|
Kiểm tra chất phóng xạ
|
Không bắt buộc
|
Bắt buộc kiểm tra
|
|
Ứng dụng trong nhà máy
|
Vệ sinh phụ trợ, làm mát gián tiếp
|
Pha chế, rửa nguyên liệu, làm đá, hơi nước
|
|
Chi phí xử lý
|
Thấp hơn 40-60%
|
Cao do cần nhiều công đoạn lọc
|
|
Tần suất kiểm nghiệm
|
Mỗi quý hoặc mỗi 6 tháng
|
Hàng tháng hoặc thường xuyên hơn
|
4.4. Các khuyến nghị liên quan
Để tránh sai sót trong quản lý chất lượng nước, các chuyên gia đưa ra những khuyến nghị sau:
Về hệ thống đường ống:
- Sơn màu khác nhau cho đường ống nước sinh hoạt (màu xanh lam) và nước sản xuất (màu xanh lục)
- Gắn biển báo rõ ràng tại mỗi điểm lấy nước
- Lắp van một chiều ngăn dòng chảy ngược giữa hai hệ thống
- Kiểm tra định kỳ các điểm nối để phát hiện kết nối sai
Về quản lý sử dụng:
- Đào tạo tất cả công nhân về sự khác biệt giữa hai loại nước
- Chỉ định trách nhiệm cho từng bộ phận về việc kiểm soát nguồn nước
- Lập quy trình lấy mẫu và kiểm tra tại các điểm sử dụng cuối
- Ghi chép đầy đủ việc sử dụng nước cho từng ca sản xuất
Về đầu tư dài hạn: Nhiều nhà máy lựa chọn đầu tư hệ thống xử lý nước đạt chuẩn QCVN 6-1:2010/BYT cho toàn bộ cơ sở.
---> Tham khảo thêm [Thông tin chi tiết về hóa chất khử Oxy cho nước nồi hơi]
Giải pháp này tuy chi phí ban đầu cao hơn 50-70% nhưng mang lại lợi ích:
- Đơn giản hóa quản lý, giảm rủi ro sử dụng sai nguồn
- Linh hoạt trong sắp xếp dây chuyền sản xuất
- Nâng cao uy tín với cơ quan thanh tra và khách hàng
- Dễ dàng mở rộng quy mô sản xuất trong tương lai

V. Giải pháp khi nguồn nước sản xuất thực phẩm không đạt chuẩn theo QCVN
Phần lớn nguồn nước thô từ giếng khoan, sông hồ hoặc ngay cả nước máy đều không đạt chuẩn QCVN 6-1:2010/BYT trực tiếp. Doanh nghiệp cần áp dụng các biện pháp xử lý phù hợp.
5.1. Kiểm định định kỳ bắt buộc
Xét nghiệm chất lượng nước là bước đầu tiên và quan trọng nhất. Không thể biết nước có đạt chuẩn hay không nếu không kiểm tra bằng phương pháp khoa học.
Quy trình kiểm định chuẩn bao gồm:
1. Lấy mẫu đúng kỹ thuật:
- Sử dụng chai vô trùng do phòng thí nghiệm cung cấp
- Lấy mẫu vào buổi sáng, trước khi hệ thống hoạt động
- Lấy ở nhiều điểm khác nhau: nguồn đầu vào, sau xử lý, điểm sử dụng cuối
- Bảo quản mẫu ở nhiệt độ 4-8°C trong thùng đá
2. Vận chuyển nhanh đến phòng thí nghiệm:
- Mẫu vi sinh phải đến phòng lab trong vòng 6 giờ
- Mẫu hóa học có thể bảo quản 24-48 giờ tùy chỉ tiêu
- Kèm theo phiếu ghi rõ thông tin: ngày giờ lấy, vị trí, người lấy mẫu
3. Chọn phòng thí nghiệm uy tín:
- Phải được Bộ Y tế hoặc Sở Y tế chỉ định
- Có chứng nhận ISO 17025 về năng lực thử nghiệm
- Sử dụng phương pháp chuẩn TCVN hoặc quốc tế
- Định kỳ kiểm tra liên phòng để đảm bảo độ chính xác
4. Phân tích kết quả:
- Đối chiếu từng chỉ tiêu với giới hạn trong QCVN
- Xác định các thông số vượt ngưỡng cần xử lý ưu tiên
- Lưu trữ hồ sơ kết quả ít nhất 3 năm
- Báo cáo cho bộ phận kỹ thuật để điều chỉnh hệ thống xử lý
Tần suất kiểm nghiệm khuyến nghị:
- Giai đoạn đầu vận hành hệ thống mới: mỗi tuần một lần
- Sau khi hệ thống ổn định: mỗi tháng một lần
- Kiểm tra đột xuất khi có dấu hiệu bất thường: mùi vị lạ, màu sắc thay đổi
- Sau mỗi lần sửa chữa, bảo trì hệ thống xử lý nước
---> Tham khảo thêm [Kiểm soát chất lượng nước cấp trong nhà máy điện tử]

5.2. Các nguồn nước có thể sử dụng
Lựa chọn nguồn nước đầu vào ảnh hưởng lớn đến chi phí và độ phức tạp của hệ thống xử lý. Dưới đây là phân tích từng loại nguồn:
Nước máy đô thị:
- Ưu điểm: Đã qua xử lý sơ bộ, có áp lực ổn định, chi phí thấp
- Nhược điểm: Chứa clo dư cao, có thể có màu vàng do ống dẫn cũ
- Xử lý cần thiết: Lọc than hoạt tính để loại clo và mùi vị, lọc tinh nếu cần đạt chuẩn cao
- Phù hợp: Các cơ sở quy mô nhỏ và vừa trong khu đô thị
Nước giếng khoan:
- Ưu điểm: Ổn định về chất lượng, ít bị ô nhiễm bề mặt
- Nhược điểm: Có thể chứa sắt, mangan, độ cứng cao, asen (vùng Đồng bằng sông Hồng)
- Xử lý cần thiết: Làm mềm nước, loại sắt-mangan, kiểm tra asen đặc biệt
- Phù hợp: Các nhà máy quy mô trung bình có diện tích đất rộng
Nước mặt (sông, hồ):
- Ưu điểm: Nguồn dồi dào, chi phí khai thác thấp
- Nhược điểm: Chất lượng dao động theo mùa, dễ ô nhiễm, độ đục cao
- Xử lý cần thiết: Lắng, lọc cát, lọc than, khử trùng mạnh
- Phù hợp: Các nhà máy lớn có đầu tư hệ thống xử lý hoàn chỉnh
Nước mưa:
- Ưu điểm: Sạch tự nhiên nếu thu hứng đúng cách, TDS rất thấp
- Nhược điểm: Không ổn định theo mùa, dung tích chứa lớn
- Xử lý cần thiết: Lọc thô loại lá cây, khử trùng UV hoặc ozone
- Phù hợp: Nguồn bổ sung cho các vùng thiếu nước, không nên làm nguồn chính
Nước tinh khiết đóng chai:
- Ưu điểm: Chắc chắn đạt chuẩn, không cần xử lý
- Nhược điểm: Chi phí rất cao, chỉ phù hợp khối lượng nhỏ
- Phù hợp: Các cơ sở sản xuất thủ công quy mô nhỏ, sản xuất thử nghiệm
---> Cùng VITEKO [Hướng dẫn cách chọn màng lọc RO phù hợp cho doanh nghiệp]

5.3. Biện pháp xử lý khi nước không đạt chuẩn
Hệ thống xử lý nước thường bao gồm nhiều công đoạn ghép nối. Mỗi công đoạn có nhiệm vụ loại bỏ một nhóm tạp chất cụ thể.
Công đoạn 1- Lọc thô (Filtration Pre-treatment): Lọc thô loại bỏ các hạt lớn trước khi nước vào các giai đoạn xử lý tinh:
- Lưới chắn rác: Giữ lại lá cây, cành cọng, rác thải lớn
- Bể lắng: Cho các hạt đất, cát, bùn lắng xuống đáy
- Lọc cát thạch anh: Giữ lại các hạt từ 20-50 micron
- Thay thế vật liệu lọc: Mỗi 6-12 tháng tùy độ đục nước đầu vào
Công đoạn 2- Lọc than hoạt tính (Activated Carbon Filtration): Than hoạt tính có cấu trúc rỗng với diện tích bề mặt cực lớn, hấp thụ các chất hữu cơ và khí:
- Loại bỏ clo dư từ nước máy
- Hấp thụ mùi vị lạ, màu sắc do tảo hoặc chất hữu cơ
- Giảm một phần các hợp chất hữu cơ bay hơi
- Tuổi thọ: 6-18 tháng, tái sinh bằng hơi nước hoặc thay mới
Công đoạn 3- Làm mềm nước (Water Softening): Sử dụng nhựa trao đổi ion để loại bỏ canxi và magie:
- Nguyên lý: Ion canxi và magie được thay thế bằng ion natri
- Giảm độ cứng từ 300-500 mg/L xuống dưới 50 mg/L
- Tái sinh: Rửa ngược bằng dung dịch muối ăn (NaCl) đặc
- Chu kỳ tái sinh: Mỗi 3-7 ngày tùy dung tích xử lý
Công đoạn 4- Lọc thẩm thấu ngược RO (Reverse Osmosis): Công nghệ RO là bước quan trọng nhất trong xử lý nước đạt chuẩn cao:
- Nguyên lý: Ép nước qua màng bán thấm áp suất 10-15 bar
- Loại bỏ: 95-99% tổng chất rắn hòa tan, muối khoáng, kim loại nặng
- Giảm TDS từ 500-1000 mg/L xuống dưới 50 mg/L
- Tỷ lệ thu hồi: 50-75%, phần còn lại là nước thải đặc
- Thay màng: Mỗi 2-3 năm, chi phí từ 20-50 triệu đồng
Công đoạn 5- Khử trùng cuối cùng: Sau khi đã loại bỏ tạp chất, cần diệt vi sinh vật còn sót lại:
- Khử trùng bằng tia UV:
- Nguyên lý: Tia UV bước sóng 254 nm phá hủy DNA vi khuẩn
- Ưu điểm: Không tạo hóa chất phụ, không thay đổi mùi vị
- Nhược điểm: Không có tác dụng dư, vi khuẩn có thể phát triển lại trong đường ống
- Bảo trì: Lau chùi đèn mỗi tháng, thay đèn mỗi 12 tháng
- Khử trùng bằng ozone:
- Nguyên lý: Khí ozone (O₃) oxy hóa mạnh, phá vỡ màng tế bào vi khuẩn
- Ưu điểm: Diệt khuẩn mạnh hơn clo, phân hủy thành oxy vô hại
- Nhược điểm: Thiết bị đắt, cần kỹ thuật viên có trình độ cao
- Nồng độ: 0.5-2 mg/L, thời gian tiếp xúc 5-10 phút
- Khử trùng bằng clo:
- Nguyên lý: Clo hòa tan tạo axit hypochlorous (HOCl) diệt vi khuẩn
- Ưu điểm: Chi phí thấp, có tác dụng dư bảo vệ trong đường ống
- Nhược điểm: Tạo mùi vị, có thể hình thành trihalomethanes (THMs) gây hại
- Nồng độ: 0.3-0.5 mg/L clo dư tại điểm sử dụng cuối
---> Tham khảo thêm [Kiểm định hệ thống nước dược phẩm: Quy trình IQ, OQ, PQ] Chi tiết

5.4. Hệ thống nước riêng biệt
Khi sử dụng cả nước sinh hoạt và nước sản xuất thực phẩm, việc ngăn tách hai hệ thống là bắt buộc:
- Yêu cầu về đường ống:
- Sử dụng ống inox 304 hoặc 316L cho nước sản xuất thực phẩm
- Ống PVC hoặc HDPE cho nước sinh hoạt
- Màu sơn phân biệt: xanh lục cho nước sản xuất, xanh lam cho nước sinh hoạt
- Gắn nhãn tại mỗi điểm rẽ nhánh, van khóa, đầu lấy nước
- Van chống dòng ngược:
- Lắp van một chiều tại điểm nước sản xuất nối vào thiết bị
- Kiểm tra hoạt động van mỗi tháng
- Thay thế van khi phát hiện rò rỉ hoặc kẹt
- Điểm lấy nước:
- Đầu nối nhanh (quick coupling) khác kiểu giữa hai hệ thống
- Khóa các vòi nước không được phép sử dụng
- Đặt biển cảnh báo lớn tại khu vực dễ nhầm lẫn
- Kiểm tra chéo:
- Định kỳ lấy mẫu nước tại các điểm nghi ngờ kết nối sai
- Sử dụng chất màu thử nghiệm để kiểm tra rò rỉ giữa hai hệ thống
- Thanh tra đột xuất bởi bộ phận chất lượng
---> Thông tin nên tham khảo [Điều chỉnh pH nước: Hóa chất & Thiết bị phù hợp]

5.5. Khắc phục và giám sát
Hệ thống xử lý nước cần được giám sát liên tục để phát hiện sớm các bất thường:
Giám sát tự động:
- Cảm biến đo pH, TDS, áp suất, lưu lượng trực tuyến
- Cảnh báo qua đèn tín hiệu hoặc còi khi thông số vượt ngưỡng
- Ghi log dữ liệu theo thời gian để phân tích xu hướng
- Kết nối với hệ thống SCADA hoặc PLC để điều khiển tự động
Vệ sinh hệ thống CIP (Cleaning In Place):
- Rửa đường ống và thiết bị định kỳ bằng dung dịch kiềm và axit
- Chu kỳ: Mỗi tuần một lần hoặc khi phát hiện màng sinh học bám
- Quy trình: Rửa kiềm (NaOH 1-2%) → Rửa nước → Rửa axit (HNO₃ 1%) → Rửa nước → Khử trùng
- Kiểm tra hiệu quả bằng phương pháp đếm số vi khuẩn trên bề mặt (swab test)
Bảo trì phòng ngừa:
- Lập kế hoạch bảo trì định kỳ cho mọi thiết bị
- Thay thế phụ tùng theo khuyến nghị nhà sản xuất
- Kiểm tra áp suất, nhiệt độ, độ rung của bơm
- Vệ sinh bể chứa, xả cặn lắng mỗi 6 tháng
Lưu trữ hồ sơ:
- Nhật ký vận hành hàng ngày: áp suất, lưu lượng, thời gian chạy
- Kết quả kiểm nghiệm định kỳ
- Lịch sử bảo trì, thay thế thiết bị
- Sự cố và biện pháp khắc phục
- Lưu trữ tối thiểu 3 năm, có thể điện tử hoặc giấy
---> Tham khảo nội dung [Nước tinh khiết USP ngành dược phẩm: Yêu cầu và cách đạt tiêu chuẩn]

5.6. Hệ thống quản lý chất lượng liên quan
Quản lý chất lượng nước không thể tách rời khỏi hệ thống quản lý an toàn thực phẩm tổng thể:
ISO 22000 - Hệ thống quản lý an toàn thực phẩm:
- Yêu cầu xác định nước là một nguồn nguy cơ tiềm ẩn
- Thiết lập chương trình tiên quyết (PRP) cho quản lý nước
- Xác định điểm kiểm soát tới hạn (CCP) liên quan đến nước
- Giám sát, xác minh và cải tiến liên tục
HACCP - Phân tích mối nguy và kiểm soát điểm tới hạn:
- Xác định mối nguy sinh học, hóa học, vật lý từ nước
- Đánh giá mức độ nghiêm trọng và khả năng xảy ra
- Xác định điểm kiểm soát tới hạn: Thường là bước khử trùng cuối cùng
- Thiết lập giới hạn tới hạn: Ví dụ clo dư 0.3-0.5 mg/L
- Thủ tục giám sát: Kiểm tra clo dư mỗi 2 giờ
- Hành động khắc phục: Dừng sản xuất nếu clo dư dưới 0.3 mg/L
GMP - Thực hành sản xuất tốt:
- Quy định về thiết kế hệ thống đường ống, bể chứa
- Yêu cầu về vật liệu tiếp xúc với nước: Inox 304/316L, không độc hại
- Đào tạo nhân viên về vệ sinh và quy trình lấy mẫu
- Kiểm soát sâu bọ, động vật gặm nhấm xung quanh bể chứa nước
Lợi ích của việc tích hợp:
- Giảm trùng lặp trong kiểm tra và giám sát
- Tăng tính nhất quán trong quản lý
- Nâng cao uy tín với khách hàng và cơ quan chứng nhận
- Dễ dàng đáp ứng yêu cầu xuất khẩu
---> Hãy tham khảo thêm về Cloramin B là gì? Cách pha Cloramin B khử trùng nước [TẠI ĐÂY]

VI. Kết luận
Tuân thủ tiêu chuẩn nước sản xuất thực phẩm theo QCVN không chỉ là yêu cầu pháp lý mà còn là nền tảng cho sự phát triển bền vững của doanh nghiệp chế biến thực phẩm. Nước đạt chuẩn QCVN 6-1:2010/BYT với 21 chỉ tiêu hóa lý và 5 chỉ tiêu vi sinh bảo vệ chất lượng sản phẩm từ khâu đầu tiên của quy trình công nghệ.
Việc phân biệt rõ ràng giữa nước sinh hoạt theo QCVN 01-1:2018/BYT và nước sản xuất thực phẩm giúp doanh nghiệp tối ưu chi phí đầu tư trong khi vẫn đảm bảo an toàn tuyệt đối. Đầu tư vào hệ thống xử lý nước hiện đại - từ lọc thô, than hoạt tính, làm mềm nước, thẩm thấu ngược RO đến khử trùng bằng UV hoặc ozone - là khoản đầu tư dài hạn mang lại giá trị cho cả doanh nghiệp và người tiêu dùng.

Tiêu chuẩn nước sản xuất thực phẩm theo QCVN là chủ đề được nhiều doanh nghiệp quan tâm khi xây dựng hệ thống kiểm soát nước dùng trong chế biến, nhằm hạn chế rủi ro và nâng cao sự tuân thủ trong vận hành. Vui lòng liên hệ Hotline 091 897 6655 (Miền Nam) hoặc Hotline 093 345 5566 (Miền Bắc) để được VITEKO tư vấn lọc nước công nghiệp chi tiết hơn.